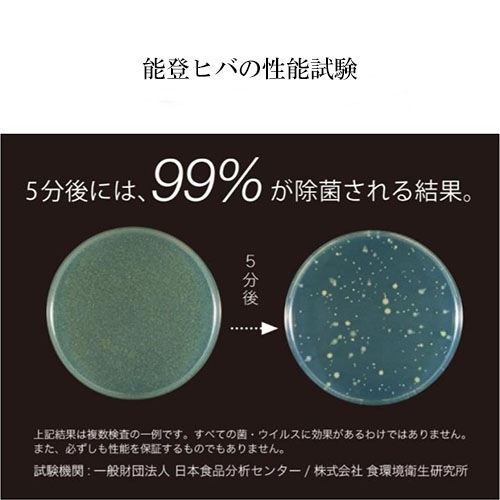

定期購入価格¥1,564

1回目以降のご購入の方にエッセンシャルウオーター500ml詰替えを差し上げます!
3ヶ月まとめ便を選んでいただいたお客様の初回限定プレゼント
156ポイント獲得できます
レビューはまだありません
数量
- アイテム説明
- 商品説明
除菌・除ウイルス・消臭成分を含み、リラックス効果のある能登ヒバの香りが広がることで心地よい環境を作ります。
能登ヒバから抽出された蒸留水のみで作られており、化学合成成分・アルコールを一切使用せず、100%の天然成分にこだわった製品です。
除菌から空間の香り付けまで幅広いシーンでご使用いただけます。
商品名 NOTOHIBAKARA エッセンシャルウォーター 内容量 200ml 成分 能登ヒバ蒸留水 抽出方法 水蒸気蒸留法 使用回数 約650回 用途 布・室内空間用


毎月定期便なら初回のお届けから 10%OFF、3 ヶ月おまとめ便なら初回のお届けから 15%OFF となります。
2 回目以降も初回と同じ値段で、お得に自動的に届きます。3 ヶ月おまとめ便なら初回時特典もお付けします。
次回発送予定日の 10 日前までならいつでもお届け内容の変更が可能です。
お客様のご都合に合わせてお好きなコースをお選びください。
変更ご希望の際は、次回のお届け日の10日までにマイページよりご変更ください。
いつでもどこでも送料無料でお届けいたします。
定期便会員様には新製品先行セールのご案内や、プレゼントキャンペーン、新製品のモニターのご案内など、楽しい特典を多数ご用意しております。
定期便コース利用規約
定期便のお届けコース(以下、「定期便コース」といいます。)とは、加賀木材株式会社(以下、「当社」といいます。)が本規約に従って、お客様に対して、定期的に、当社が指定する製品(以下、「対象製品」といいます。)をお届けするサービスです。なお、お客様が対象製品を定期便コースで購入された場合は、本規約が適用されます。
第1条(目的・適用)
1. 本規約は、当社がお客様に対して、定期便コースを提供するにあたり、その諸条件を定めるものです。
2. 定期便コースは、本規約のほか、当社が別途定める条件(以下、「個別条件」といいます。)に基づき提供されます。なお、個別条件によって本規約に定める定期便コースと異なる条件のコースが設定される場合があります。
第2条(定期便コースについて)
1. 定期便コースは一度の注文により、以後定期的に対象製品をお届けするサービスとなり、製品のお届けごとに第6条に従って代金をお支払いいただくものです。なお、2回目以降のお届けについては、本条第3項及び第4項の定めに従います。
2. 定期コースによる対象製品(一部対象製品は除く)のお届けは、お申込み内容に応じ原則として「毎月」又は「隔月」又は「その他」にお届けします。
3. 2回目以降のお届けについては、当社に対してご連絡をいただくことにより休止(定期コースの休止)または解約(定期コースの解約)することが可能です。休止または解約を希望する場合には、お届け予定日の10日前までにご連絡ください(休止・解約のご連絡は電話で受け付けております)。お届け予定日の10日前を過ぎてからご連絡があった場合においては、当該予定日の次の予定日からの中止を受け付けいたします。
4. 2回目以降のお届けについては、前項に記載のある休止及び解約のご連絡をいただくまで、同じ条件で自動的に継続してお届けいたします。
第3条(ご注文について)
1. 定期便コースのお申込内容に応じて「毎月」または「隔月」または「その他」のご指定の日に自動的に製品をお届けいたします。ただし、交通事情、休日・祝日等により、お届け日がご指定日の前後になることもあります。
2. 定期便コースのご利用期間中は、定期購入製品およびその他の製品等が5%から30%の割引(一部対象製品は除く)の範囲内でご購入いただけます。なお、お買い得製品等には割引が適用されない場合がございますので、あらかじめご了承ください。
3. 製品のご注文はインターネットにて受け付けております。
第4条(送料について)
定期便コースのご利用期間中の対象製品は、全国送料無料でお届けいたます。(一部対象製品は除きます。)
第5条(お届けについて)
1. お届け先は申込の際にご登録いただいた住所となります。お届け先に変更がある場合は、お届け予定日の10日前までにインターネットまたは電話にてお申し出ください。
2. お届け日の変更ができます。お届け予定日の10日前までにお申し出ください。お届け予定日の10日前を過ぎてからのお申し出の場合においては、当該予定日の次のお届けから変更を行います。
第6条(お支払方法)
1. クレジットカードがご利用いただけます。ご利用の際はカード番号、有効期限などをご確認させていただきます。ご利用可能なクレジットカードは、VISA/JCB/MasterCardのマークがついているカードとなります。各クレジットカード会社の所定の日にお客様の口座等からお支払いしていただくことになります。
2. 銀行振込がご利用いただけます。銀行振込の手数料はお客様のご負担でお願い致します。お振込み先は下記指定銀行口座となります。北國銀行 本店営業部 普通預金 口座番号 675596 カガモクザイ・カ
第7条(初回限定購入の20日間返金保証について)
1.万が一、返金保証となる対象製品がお客様に合わない場合はお電話でお申し出ください。注文日から20日以内のご連絡受付の場合、『20日間返金保証』の対象となります。
2.上記保証の適用条件を満たす製品などのご返却を確認の上で、代金返却その他の必要な措置をとるものとし、次回お届けより中止させていただきます。尚、返送にかかる費用及び手数料等はお客様のご負担でお願い致します。
第8条(個人情報の利用)
お客様の個人情報は、当社及び委託先からの事務連絡、各種ご案内、発送に伴う業務等に利用し、第三者提供することはありません。なお、プライバシーポリシーの詳細については、「個人情報保護ポリシー」をご参照いただき、ご同意の上お申し込みください。
第9条(返品・交換について)
1. 製品の返品・交換のお申込みは、製品到着後7日以内に事前に必ずお電話にてご連絡ください。
2. 一度ご利用になった製品または開封後の製品等を除き、未使用の製品に限り返品・交換をさせて頂きます。ただし、当社の責任による返品・交換の場合にはこの限りではありません。
第10条(定期便コースの停止・中断)
当社は次の各号に該当する場合、お客様に事前に通知せず、定期便のコース提供を停止または中断できるものとします。この場合、当社の責任による場合を除き、お客様に生じた損害について、当社は一切責任を負わないものとします。
(1)戦争、地震、火災、停電その他の非常事態により、定期便コースの提供が通常どおり出来なくなった場合。
(2)製品の欠品、終売等のやむを得ない事情により、定期便コースの提供が通常どおり出来なくなった場合。
(3)その他、当社が定期便のコース運営上、一時的な中断が必要と判断した場合。
第11条(定期便コースの変更・終了)
1. 当社が必要であると判断した場合、お客様に事前に通知せず、定期便コースの内容、提供条件または本規約の変更を行うことがあります。変更事項は、当社の定める告知媒体、公式ウェブサイトの告知ページまたはその他の方法により、お客様へ告知します。
2. 当社は、当社の都合により定期便コースを終了することがあります。この場合、当社は、当社の定める告知媒体、公式ウェブサイト内の告知ページまたはその他の方法により、お客様に事前に告知します。
3. お客様は、前各項について、予めこれを承諾するものとします。
4. 当社は、本条第1項及び第2項の規定に基づきお客様の定期便コースの変更・終了した場合、当社の責任による場合を除き、お客様に生じた損害について、当社は一切責任を負わないものとします。
第12条(免責)
当社が定期便コースに関連して当社の責めに帰すべき事由によりお客様に損害を与えた場合における損害賠償義務の範囲は、当社がお客様から定期便コースに関連して受領した料金の総額を上限とし、かつ定期便コースの利用によりお客様に直接的に生じた通常損害(付随的損害、特別損害、遺失利益、その他間接的に発生した損害については、それらの予見または予見可能性の有無にかかわらず含まない。)に限定されるものとします。ただし、当該損害の発生が当社の故障又は過失に起因する場合はこの限りではありません。
第13条(転売等目的での購入等禁止)
当社は、品質及び衛生保持の観点から、当社製品の転売、オークションへの出品等の当社製品(サンプル等含む)の譲渡およびお申込みをお断りしています。
第14条(準拠法及び合意管轄)
本規約は日本法を準拠法とし、日本法に従って解釈されるものとします。また、本規約の履行および解釈に関し紛争が生じたときは、金沢地方裁判所を第一審の専属的合意管轄裁判所とします。
-
- システム商品コード
- :000000000041
-
- 製造元
- :加賀木材株式会社
-
- 原産地
- :日本
-
- 目安送料
- :500円~